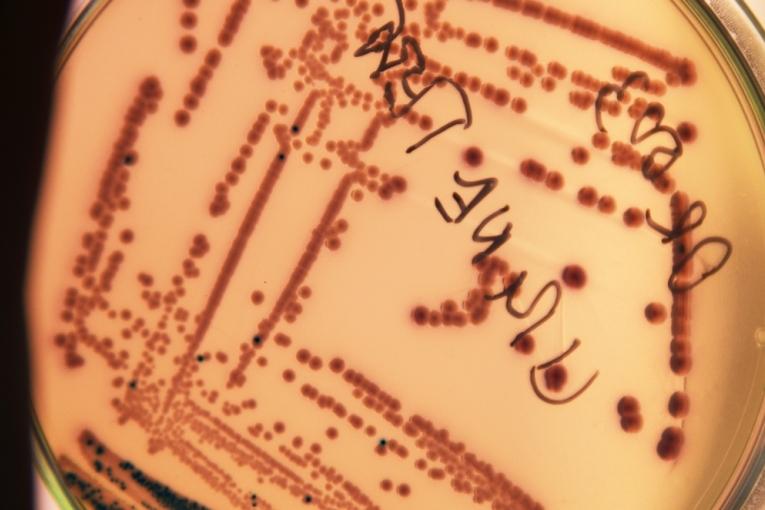

Résistance aux antibiotiques : une priorité de santé mondiale désormais reconnue par les Nations unies
Communiqué de presse
La Réunion de haut niveau des Nations Unies qui s’est tenue aujourd’hui à New York est la première à porter à un niveau d’attention politique aussi élevé le problème des infections résistantes aux antibiotiques – et seulement la quatrième dédiée à un sujet de santé globale dans l’histoire des Nations Unies.
La déclaration politique qui a été adoptée suite à la réunion souligne le besoin de mieux utiliser les antibiotiques existants, en renforçant les systèmes de santé et les capacités de diagnostic ; recommande d’améliorer l’accès aux médicaments et vaccins existants, susceptibles de réduire le nombre d’infections et le besoin d’antibiotiques ; et appelle à ce que la recherche et développement dans ce domaine permettent d’obtenir des produits accessibles et abordables pour tous les patients.
« MSF salue la Déclaration politique des Nations Unies sur la résistance aux antibiotiques, en ce qu’elle reconnaît le besoin de répondre au plus haut niveau politique au problème complexe et mondial des infections résistantes aux antibiotiques. Les Etats ont maintenant la responsabilité de transformer ces intentions en actes, et de mettre en place les plans définis à l’échelle nationale et les engagements globaux en la matière, explique le Dr. Joanne Liu, Présidente internationale de Médecins Sans Frontières.
Les équipes de MSF sont confrontées aux infections résistantes aux antibiotiques partout dans le monde : en Jordanie, où elles soignent des blessés de guerre ; au Pakistan, chez les nouveau-nés ; en Haïti, où elles prennent en charge les grands brûlés ; ou encore en Afrique du Sud, chez les patients atteints de tuberculose multi-résistante. Certaines de ces infections ne peuvent être soignées qu’avec des antibiotiques dits ‘de dernière ligne’, soit utilisés en dernier recours.
Nous devons tous continuer de travailler pour utiliser les médicaments existants de façon appropriée, pour élargir l’accès à des tests de diagnostic plus précis, et pour que l’accès aux antibiotiques, existants ou nouveaux, soit garanti à tous les patients. Les Etats et les laboratoires peuvent également agir dès maintenant pour traiter le problème en amont, par exemple en mettant à disposition le vaccin contre les pneumonies à un prix abordable, pour prévenir davantage de pneumonies chez les enfants ; et en améliorant les protocoles de traitement nationaux de la tuberculose, pour améliorer la prévention et le traitement des formes résistantes de la maladie, poursuit le Dr. Liu.
Enfin, MSF constate avec satisfaction que cette déclaration prend en compte les conclusions du récent rapport du Groupe de haut niveau sur l’Accès aux médicaments établi par le Secrétaire Général, en reconnaissant l’échec du système actuel de recherche et développement, et en intégrant d’importants engagements en matière de santé publique, qui visent à assurer que de nouveaux antibiotiques , vaccins et outils de diagnostic nécessaires à contrôler l’antibiorésistance seront disponibles et abordables pour les patients qui en ont le plus besoin. MSF se réjouit également que la déclaration appelle à séparer les coûts de recherche et développement des prix pratiqués sur les produits et outils médicaux, et à assurer qu’un retour public est assuré lorsque des fonds publics sont utilisés pour développer de nouveaux produits ».
MSF participe aux efforts globaux visant à endiguer la propagation des infections résistantes aux antibiotiques en développant ses capacités de diagnostic des infections bactériennes, en améliorant l’utilisation des antibiotiques, en renforçant l’hygiène hospitalière pour réduire la transmission des infections, en documentant la fréquence et la nature des résistances, et en soutenant les initiatives visant à développer de nouveaux outils de diagnostic et de traitement plus abordables.


